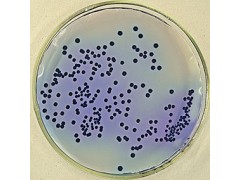

产品简介
氯化钠结晶紫增菌液产品说明及用途培养基(Medium)是供微生物、植物和动物组织生长和维持用的人工配制的养料,一般都含有培养基
公司简介
上海信裕生物科技有限公司是一家生物高新技术企业,主要从事免疫学、分子生物学和常规生化试剂的研发、销售。并代理销售Amresco,qiagen,GenWay,Sciencell,Millipore,eBioscience,Sigma、R&D、GBD、ATCC、HYCLONE等二十多家国内外知名品牌,致力于为广大高校、科研院所和企业单位提供的科研试剂和完善的技术服务,满足生物化学、分子生物学 、细胞生物学、免疫学 ELISA试剂盒等生物科技实验需求。
上海信裕先后与天津中医学院、复旦大学、上海交通大学医学院、上海交通大学、华东师范大学、第二军医大学、南京大学,暨南大学,南京工业大学,曙光医院、华山医院、瑞金医院、上海有机研究所、中科院上海分院等多家单位建立了良好的合作关系。本公司可为您提供科研ELISA试剂盒,种属标本齐全,有专门针对人血清、血浆、全血、分泌物、尿液、细胞培养上清液、组织匀浆、组织液等标本的试剂盒;另有针对各种动物(鼠、兔、牛、马、鸡、猪、狗、山羊、猴、鱼)的科研试剂。
公司秉承“专注品质、信守承诺、积极沟通、创新服务”的企业文化积极参与生物领域的技术创新和技术服务,力求为我国科研事业,专业的服务!
其主营产品:ELISA试剂盒/人ELISA试剂盒/大鼠ELISA试剂盒/小鼠ELISA试剂盒/金标试剂盒/免疫组化试剂盒/标准品/科研抗体/生化试剂,生物培养基/细胞株/实验室耗材/动物血清等科研产品
展开
产品说明
氯化钠结晶紫增菌液产品说明及用途
培养基(Medium)是供微生物、植物和动物组织生长和维持用的人工配制的养料,一般都含有培养基有碳水化合物、含氮物质、无机盐(包括微量元素)以及维生素和水等。有的培养基还含有抗菌素和色素。
【一般贮存】必须防潮、避光、阴凉处保存
【组织培养基贮存】较长时间的贮存,必须放在2~6℃的冰箱内
【注意事项】:由于液体培养基不易长期保管,现在均改制成粉末。
氯化钠结晶紫增菌液产品展示:
11218 TGY 琼脂培养基Tryptone Glucose Yeast Agar Medium 250g/瓶
12102 芽孢杆菌培养基基础芽庖桿菌培地基礎Bacillus Medium Base 250g/瓶
11215 溴甲酚紫琼脂(BPA)ブロムクレゾールパーブル寒天Bromocresol Purple Agar 250g/瓶
11012 锰盐营养琼脂マンガン塩普通寒天Mn2+ Nutrient Agar 250g/瓶
11208 改良亚硫酸盐琼脂変法亜硫酸塩寒天Modified Sulfite Agar 250g/瓶
11207 葡萄糖胰蛋白胨琼脂ブドウ糖ペプトン寒天Glucose Tryptone Agar 250g/瓶
11211 葡萄糖蛋白胨琼脂(DT 培养基,不含中和剂)ブドウ糖ペプトン寒天(DT 培地、中和剤を含まない)DT Medium 250g/瓶
10127 DTA 培养基DTA 培地DTA Medium 250g/瓶
11220 NGKG 琼脂基础NGKG 寒天基礎NGKG Agar Base 250g/瓶
42
放线菌
编号 产品名称 规格
12602 胰蛋白胨酵母浸粉肉汤ISP Medium 1(Tryptone Yeast Extract Broth) 250g/瓶
12108 高氏合成一号琼脂培养基高氏合成一号寒天培地Gause's Synthetic Agar Medium 250g/瓶
12603 酵母膏-麦芽膏琼脂ISP Medium 2(Yeast Extract Malt Extract Agar) 250g/瓶
12604 无机盐淀粉琼脂ISP Medium4(Inorganic Salts-Starch Agar) 250g/瓶
12605 甘油天门冬素琼脂基础ISP Medium 5( Glycerol Asparagine Agar Base) 250g/瓶
12606 酪氨酸琼脂培养基基础ISP Medium 7( Tyrosine Agar Medium Base) 250g/瓶
12607 黄豆粉液体培养基 250g/瓶
12608 黄豆粉琼脂培养基 250g/瓶
12609 淀粉铵盐培养基 250g/瓶
43
军团菌
编号 产品名称 规格
12112 BCYE 琼脂基础BCYE 寒天基礎Buffered Charcoal Yeast Extract Agar Base 100g/瓶
22105 BCYE 鉴别琼脂添加剂BCYE 鑑別寒天添加剤BCYE Differential Agar Supplement 1ml×10 支/盒
12114 BCYE-Cys 琼脂BCYE-Cys 寒天Buffered Charcoal Yeast Extract Agar without L-cysteine 100g/瓶
12113 GVPC 琼脂基础GVPC 寒天基礎Buffered Charcoal Yeast Extract Agar Base 100g/瓶
12125 硝酸铁琼脂硝酸鉄寒天Ferric Nitrate Agar 250g/瓶
44
支原体
编号 产品名称 规格
12119 支原体肉汤培养基マイコプラズブイヨン基礎Mycoplasma Broth Medium 250g/瓶
12120 精氨酸支原体肉汤培养基マイコプラズマブロス培地Mycoplasma Broth Medium with Arginine 250g/瓶
12121 支原体半流体培养基マイコプラズマ半流動培地Mycoplasma semifluid Medium 250g/瓶
12122 支原体琼脂培养基マイコプラズマ寒天培地Mycoplasma Agar Medium 250g/瓶
12123 PPLO 肉汤基础PPLO ブイヨン基礎PPLO Broth 250g/瓶
12124 PPLO 琼脂基础PPLO ブイヨン基礎PPLO Agar Base 250g/瓶
12148 支原体肉汤基础(Frey)マイコプラズブイヨン基礎Mycoplasma Broth Medium(Frey) 250g/瓶
12149 肺炎支原体肉汤基础肺炎マイコプラズマブイヨン基礎Mycoplasma pneumoniae Broth Base 250g/瓶
12150 解脲支原体肉汤基础マイコプラズマ・ウレアリチクムブイヨン基礎Ureaplasma urealyticum Broth Base 250g/瓶
12172 解脲支原体琼脂基础 250g/瓶
45
鼠疫杆菌
编号 产品名称 规格
12129 亚硫酸钠琼脂亜硫酸ナトリウム寒天Sodium Sulfite Agar 250g/瓶
12130 龙胆紫血液琼脂基础CVB 寒天基礎Crystal Violet Blood Agar Base 250g/瓶
12131 溶血琼脂基础溶血寒天基礎Hemolysis Agar Base 250g/瓶
12132 赫氏培养基ヒ氏培地Hiss Agar 250g/瓶
12133 赫氏增菌液ヒ氏増菌ブイヨンHiss Enrichment Broth 250g/瓶
46
炭疽杆菌
编号 产品名称 规格
12118 溶菌酶多粘菌素琼脂基础LPA 寒天基礎Lysozyme Polymyxin Agar Base 250g/瓶
12101 戊烷脒多粘菌素琼脂基础PAP 寒天基礎Pentane Amidines Polymyxin Agar Base 250g/瓶
12126 碳酸氢钠琼脂基础燐酸水素ナトリウム寒天基礎Sodium Bicarbonate Agar Base 250g/瓶
12127 指示选择性培养基基础選択性培地基礎Direct selective medium base 250g/瓶
12128 PLET 琼脂基础PLET 寒天基礎PLET Agar Base 250g/瓶
47
结核杆菌
编号 产品名称 规格
12134 改良罗氏培养基基础変法 L-J 培地基礎Lowenstein-Jensen Medium Base, Modified 250g/瓶
12135 酸性 L-J 培养基基础酸性 L-J 培地基礎Acid L-J Medium Base 250g/瓶
12136 碱性 L-J 培养基基础アルカリ性 L-J 培地基礎Alkaline L-J Medium Base 250g/瓶
12165 Dubos 肉汤基础Dubos Broth Base 250g/瓶
22111 Dubos 肉汤基础添加剂 5ml×10 支/盒
12166 Dubos 油酸琼脂基础Dubos Oleic Agar Base 250g/瓶
22112 Dubos 油酸琼脂基础添加剂 5ml×10 支/盒
12160 小川氏培养基基础 250g/瓶
48
分枝杆菌
编号 产品名称 规格
12137 Middle Brook 7H10 琼脂基础Middle Brook 7H10 寒天基礎Middle Brook 7H10 Agar Base 250g/瓶
12138 Middle Brook 7H11 琼脂基础Middle Brook 7H11 寒天基礎Middle Brook 7H11 Agar Base 250g/瓶
12163 Middlebrook 7H9 肉汤基础Middlebrook 7H9 Broth Base 250g/瓶
22113 Middlebrook ADC 增菌液Middlebrook ADC Enrichment 20ml×20 支/箱
22114 Middlebrook OADC 增菌液Middlebrook OADC Enrichment 20ml×20 支/箱
12179 Lowenstein-Jensen 培养基基础Lowenstein-Jensen 培地基礎Lowenstein-Jensen Medium Base 250g/瓶
12177 酸性 L-J 培养基基础酸性 L-J 培地基礎Acid L-J Medium Base 250g/瓶
12178 碱性 L-J 培养基基础アルカリ性 L-J 培地基礎Alkaline L-J Medium Base 250g/瓶
淋病奈瑟菌
编号 产品名称 规格
12139 双抗巧克力琼脂基础BC 寒天基礎Bi-Anti Chocolate Agar Base 250g/瓶
12141 巧克力血琼脂培养基基础CBA 培地基礎Chocolate Blood Agar Medium Base 250g/瓶
12142 淋病奈瑟菌琼脂培养基基础N.gonorrhoeae 寒天培地基礎N.gonorrhoeae Agar Medium Base 250g/瓶
12143 淋病奈瑟菌增菌培养基基础N.gonorrhoeae 増菌培地基礎N.gonorrhoeae Enrichment Medium Base 250g/瓶
12176 Thayer-Martin 选择性琼脂基础(MTMⅡ琼脂基础)Thayer-Martin Selective Agar Base ( ModifiedThayer-Martin Selective(MTMⅡ) Agar Base) 250g/瓶
49
22119 IsoVitaleX 添加剂IsoVitaleX Enrichment 1ml×10 支/盒
22120 V-C-N 抑菌剂V-C-N Inhibitor 1ml×10 支/盒
22121 三甲氧苄胺嘧啶乳酸盐Trimethoprim Lactate 0.5mg×10 支/盒
抗生素检验、药敏试验用培养基
编号 产品名称 规格
氯化钠结晶紫增菌液
本页产品地址:http://www.geilan.com/sell/show-2034871.html

![]()
 免责声明:以上所展示的[ 氯化钠结晶紫增菌液]信息由会员[上海信裕生物科技有限公司]自行提供,内容的真实性、准确性和合法性由发布会员负责。
免责声明:以上所展示的[ 氯化钠结晶紫增菌液]信息由会员[上海信裕生物科技有限公司]自行提供,内容的真实性、准确性和合法性由发布会员负责。